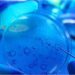
مخلوق صغير غريب لديه قواسم مشتركة مع أسلاف النمل

استأنف دفاع إحدى المدونات في المغرب على الحكم الصادر ضدها في “الإساءة للدين الإسلامي”، عن طريق نشر تدوينات عبر “فيسبوك”.
وفي تصريح لصحيفة “هسبريس” عبر شقيقها عن أمله في أن “تأخذ المحكمة بعين الاعتبار أقوال شقيقته المسجلة في محاضر الشرطة، وخاصة ما يتعلق بتشبثها بثوابت المغرب ودستور المملكة، وبالملكية”، موضحا أنها “تعتبر ما نشرته في صفحتها على فيسبوك لا يعدو أن يكون حرية تعبير ونقاشا حول أفكار، بالإضافة إلى أنها تؤمن بالفكر العلماني”.
ولفت إلى أن شقيقته “لم يسبق لها أن انتمت إلى أي هيئة دعوية أو جماعة دينية كما يروج البعض، فيما سبق لها أن ترشحت باسم حزب التقدم والاشتراكية خلال انتخابات المجالس الجهوية لسنة 2015”.
وتعيش المدونة، التي تواجه حكما قضائيا بسنتين حبسا نافذا، وعمرها لا يتجاوز 39 سنة، بشكل مستقل عن أسرتها، كما أنها مقاولة تملك شركة خياطة وتستعد لتطوير شركة تجميل أسستها حديثا.
وأشار المتحدث إلى أن شقيقته “لم تعش وسط جو متشدد، وترعرعت وسط أسرة مغربية في تقاليدها منفتحة في فكرها، قبل أن تختار العيش بشكل مستقل”.
وأكد أن “مواقع التواصل الاجتماعي تغزوها عشرات الأخبار الزائفة، ومعظم من يستعملون حساباتهم يكتبون ويدونون دون أن يكون لهم علم بأن ما ينشرونه قد يجرهم للمحاسبة القانونية”، داعيا إلى “العمل على توعية المواطنين بمضامين قانون الصحافة والنشر، وبالعقوبات المنصوص عليها، تفاديا للاصطدام مع هذه الأحكام بعد أن يتم اعتقالهم بسبب منشور يحمل إساءة غير مقصودة”.

Discussion about this post